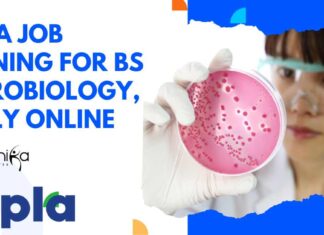
Cipla Job Opening For BSc Microbiology, Apply Online Cipla Job Opening For BSc

Biocon Biologics Walk-In-Drive For MSc Biotech & Life Sciences – Register...
Biocon Biologics Walk-In-Drive Bengaluru For MSc Biotech & Life Sciences - Register Now!
WE ARE HIRING!
Walk-In Interview: Bengaluru
Job Location: Electronic City, Bengaluru Biocon Biologics™
Experience Required:...
Baxter Microbiology Associate Role – Apply Online
Baxter Microbiology Associate Job Opening - Apply Online
Sr Assoc, Microbiology
Req #: JR - 158496
Location: Ahmedabad, Gujarat, India
Job Category: Microbiology
Date posted: 01/20/2025
Join us at the...
Reliance Life Sciences Hiring For Clinical Research Team – Apply Online
Reliance Life Sciences Clinical Research Job - Apply Online
Exciting Opportunity to Join Reliance Life Sciences – Clinical Research Team!
Are you a skilled Bioanalytical Quality...
Biotecnika Times Newsletter 20.01.2025 – Freshers QC Jobs, Intas Pharma, ICON...
Freshers Jobs at Nat Habit – Apply Online for QC
Exciting QC microbiology job opportunities for freshers. Apply now!
Intas Pharma QC Role – BTech, MSc...
CDFD Recruitment of Technical Associates For BSc & BTech – Apply...
CDFD Associates Job Openings For BSc & BTech - Apply Now
Recruitment of Technical Associates
We are planning to hire two Technical Associates to be deployed...
Cipla Job Opening For BSc Microbiology, Apply Online
Cipla Job Opening For BSc Microbiology, Apply Online
Team Member - Microbiology
Posting Date: 18 Jan 2025
Country: India
State: Sikkim
Location: Rangpo
Req Id: 90034
Job Purpose
Execute analysis of allocated...
Dr. Reddy’s Laboratories Regulatory Affairs Associate Job – Life Sciences, Bioinformatics...
Dr. Reddy's Laboratories Bioinformatics Jobs - Apply Online For Regulatory Affairs Associate Role
Regulatory Affairs Associate
Greater Kolkata Area
Job Summary
We are looking for an individual to...
Top Skills You Need For a Successful Molecular Biology Career in...
Top Skills You Need for a Molecular Biology Career in India
Priya sat under the dim glow of a microscope in a small lab near...
Bayer Product Research Scientist Role For Agri Science & Biology –...
Bayer Agri Science Jobs, Biology Apply Online For Product Research Scientist
At Bayer we’re visionaries, driven to solve the world’s toughest challenges and striving for...
JNCASR Project Oriented Biology Education (POBE) 2025 – Applications Open!
JNCASR POBE 2025 Applications Open - Project Oriented Biology Education
About POBE
As part of its Science Outreach Programme, Jawaharlal Nehru Centre for Advanced Scientific Research...
Intas Pharma QC Role – BTech, MSc & MTech Apply Now!
Intas Pharma QC Job For Biotech - BTech, MSc & MTech Apply Now!
Be a Part of a Winning Team
Join Intas' Talent Network.
As one of...
ICON plc Clinical Data Jobs – BSc Life Sciences Apply Online
ICON plc Clinical Data Jobs - BSc Life Sciences Apply Online
CDC II
Trivandrum
JR126601
Clinical Data Management ICON Full Service & Corporate Support Office Based
About the Role
CDC...
Freshers Jobs at Nat Habit – Apply Online for QC
Freshers QC Microbiology Jobs at Nat Habit - Biotech & Food Tech Apply Online
Quality Control – Microbiologist and Analyst
Gurugram, Haryana, India
About the job
About Nat...
Aravind Medical Research Foundation (AMRF) Hiring For ICMR-Funded Project Vacancy, Applications...
AMRF Madurai Project Vacancy In ICMR-Funded Project, Applications Invited
ARAVIND MEDICAL RESEARCH FOUNDATION
No.1, Anna Nagar, Madurai – 625 020
ADVERTISEMENT
Aravind Medical Research Foundation (AMRF), Madurai, is...
Sanofi Data Standards Analyst Job For Life Sciences, Apply Online
Sanofi Data Analyst Job For Life Sciences, Apply Online
Data Standards Analyst
Hyderabad, India
Permanent
Posted on: Jan. 17, 2025
Closing on: Mar. 05, 2025
The Data Standards Analyst represents...